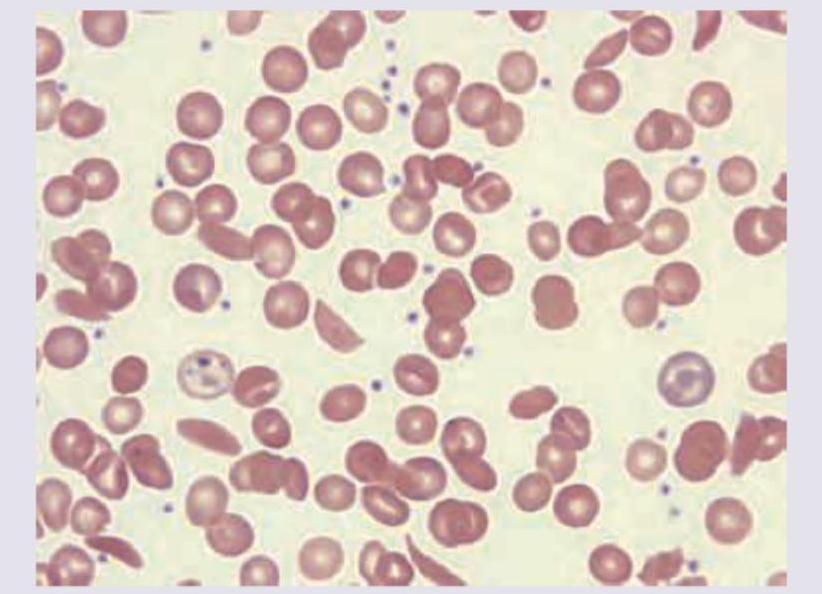
Image for question 5

NEET-PG 2017 — General Medicine
22 Previous Year Questions with Answers & Explanations
Which of the following finding is shown in the chest leads?

Cannon A waves are seen in the JVP of a patient. ECG shows:

A patient develops missed beats after thrombolysis for MI. ECG shows:

A 12-year-old child with renal tubular acidosis type I is having muscle cramps and weakness. ECG shows all except:

The patient with the following hematological abnormality presents with severe chest pain and difficulty in breathing. All are useful for managing this emergency except:
All of the following statements regarding this image are true except:

A 79-year-old male presented to the emergency department after a facial trauma. The patient had Parkinson's disease and atrial fibrillation and was on treatment with acetylsalicylic acid for AF. The image shows? (Recent NEET Pattern 2016-17)

Identify the lesion. (Recent NEET Pattern 2016-17)

A 55-year-old diabetic patient develops sudden onset hemiparesis and facial asymmetry. NCCT scan shows:

A 35-year-old woman presents with breathlessness at rest. She also complains of a skin lesion on nose which has increased in size for last 6 months. What is the diagnosis?

NEET-PG 2017 - General Medicine NEET-PG Practice Questions and MCQs
Question 1: Which of the following finding is shown in the chest leads?
- A. Myocardial ischemia
- B. Myocardial injury
- C. Digoxin (Correct Answer)
- D. Digoxin toxicity
Explanation: ***Digoxin*** - The ECG shows a characteristic **downward sloping ST segment depression** with a "sagging" or "scooped" appearance, often referred to as a **"Salvador Dali mustache"** appearance, which is typical of digoxin effect on the ECG. - This pattern is due to the drug's effect on **myocardial repolarization**, specifically shortening the QT interval and inducing these ST changes, even in the absence of toxicity. *Myocardial ischemia* - Myocardial ischemia typically manifests as **ST segment depression** that is **horizontal** or **downsloping** but usually not with the characteristic "scooped" appearance seen with digoxin. - T-wave inversions may also be present, which are not the primary finding here. *Myocardial injury* - Acute myocardial injury is characterized by **ST segment elevation** (in acute myocardial infarction) or **significant ST depression with T-wave inversions** (in NSTEMI) which differs from the morphology seen in this ECG. - The morphology of the ST segment in myocardial injury is usually more abrupt and not "scooped" like a digoxin effect. *Digoxin toxicity* - While this ECG shows a digoxin effect, **digoxin toxicity** usually presents with **arrhythmias** (e.g., ventricular premature beats, bradycardia, AV blocks) in addition to altered ST-T wave morphology. - The ECG alone, showing only repolarization changes characteristic of digoxin, does not confirm toxicity without clinical correlation or evidence of arrhythmias.
Question 2: Cannon A waves are seen in the JVP of a patient. ECG shows:
- A. First degree heart block
- B. Second degree heart block
- C. Third degree heart block (Correct Answer)
- D. Mobitz II heart block
Explanation: ***Third degree heart block*** - **Cannon A waves** in the JVP occur when the right atrium contracts against a closed tricuspid valve, which happens when atrial and ventricular contractions are **dissociated** as seen in **complete heart block**. - In the provided ECG, there is complete dissociation between P waves (atrial activity) and QRS complexes (ventricular activity), with P waves occurring regularly but independently of the QRS complexes, which signifies a **third-degree (complete) heart block**. *First degree heart block* - Characterized by a **prolonged PR interval** (>0.20 seconds) where every P wave is followed by a QRS complex. - There is no dissociation of P waves and QRS complexes, and therefore no cannon A waves due to atrial contraction against a closed tricuspid valve. *Second degree heart block* - Involves some P waves not being followed by a QRS complex, indicating **intermittent conduction failure**. - There can be Wenckebach (Mobitz I) or Mobitz II, both of which involve some degree of P-wave-QRS coupling, usually not leading to constant or prominent cannon A waves. *Mobitz II heart block* - Defined by intermittently **dropped QRS complexes** without progressive PR lengthening, often with a constant PR interval before the drop. - While some dropped beats occur, there is still a clear relationship between the P waves and the conducted QRS complexes, which differs from the continuous and complete AV dissociation seen with cannon A waves in third-degree block.
Question 3: A patient develops missed beats after thrombolysis for MI. ECG shows:
- A. Mobitz I heart block (Correct Answer)
- B. Mobitz II heart block
- C. Complete heart block
- D. Sick sinus syndrome
Explanation: ***Mobitz I heart block*** - The ECG shows a **progressive lengthening of the PR interval** before a QRS complex is dropped (missed beat), which is characteristic of Mobitz type I (Wenckebach) heart block. - This type of block is often **benign** and located in the AV node, frequently resolving spontaneously, especially after thrombolysis for an inferior MI. *Mobitz II heart block* - Characterized by **sudden, unexpected dropped QRS complexes** without prior PR interval lengthening. - Mobitz II usually indicates a block below the AV node (infranodal) and is considered more serious, often requiring a pacemaker. *Complete heart block* - In complete (third-degree) heart block, there is **no conduction between the atria and ventricles**, meaning P waves and QRS complexes are completely dissociated. - The ventricular rhythm is typically slow and independent of the atrial rhythm, which is not seen here as some P waves conduct. *Sick sinus syndrome* - Sick sinus syndrome is a **dysfunction of the SA node**, leading to various arrhythmias such as sinus bradycardia, sinus arrest, or sinoatrial block. - While it can cause missed beats, the ECG pattern here specifically points to a problem with AV conduction (PR interval changes and dropped QRS), not primary sinus node dysfunction.
Question 4: A 12-year-old child with renal tubular acidosis type I is having muscle cramps and weakness. ECG shows all except:
- A. T wave inversion with U waves
- B. ST depression
- C. Heart rate of 75 beats per minute
- D. Absent P waves (Correct Answer)
Explanation: ***Absent P waves*** - **Hypokalemia (low potassium)**, common in renal tubular acidosis type I, does not typically cause absent P waves. Absent P waves are characteristic of certain **atrial arrhythmias** or severe **hyperkalemia** with sine wave formation. - The image provided clearly shows visible P waves before each QRS complex, indicating **sinus rhythm** and normal atrial depolarization. *T wave inversion with U waves* - **Hypokalemia** can cause characteristic ECG changes including **T wave flattening**, **T wave inversion**, and prominent **U waves**, especially in leads V2-V4. - The provided ECG shows evidence of T wave flattening or inversion and visible U waves, which are consistent with hypokalemia. *ST depression* - **ST depression** can occur in cases of significant **hypokalemia**, particularly when potassium levels are very low. - The ECG shows some subtle **ST segment depression**, especially in leads like V3, which is a recognized finding in hypokalemia. *Heart rate of 75 beats per minute* - To calculate the heart rate, count the number of large squares between two R waves (e.g., in V5, there are approximately 4 large squares). The heart rate is 300 / number of large squares = 300 / 4 = **75 bpm**. - A heart rate of 75 bpm is a **normal sinus rhythm** and is not inconsistent with hypokalemia.
Question 5: The patient with the following hematological abnormality presents with severe chest pain and difficulty in breathing. All are useful for managing this emergency except:
- A. Partial exchange transfusion
- B. Morphine
- C. Hydroxyurea
- D. Packed RBC (Correct Answer)
Explanation: ***Packed RBC*** - Transfusing **packed red blood cells** will increase the overall hemoglobin concentration, which can paradoxically increase blood viscosity and worsen vaso-occlusion in sickle cell crisis, especially in the setting of acute chest syndrome where fluid overload is a concern. - This is generally avoided as a first-line treatment for acute chest syndrome in sickle cell anemia unless the patient has severe anemia with a hemoglobin level significantly below their baseline. *Partial exchange transfusion* - **Partial exchange transfusion** is a critical intervention during sickle cell crises with severe complications like acute chest syndrome. - It rapidly reduces the percentage of **sickle hemoglobin (HbS)** and concurrently provides normal red blood cells, improving oxygen-carrying capacity and reducing blood viscosity without significantly increasing total red blood cell mass. *Morphine* - **Morphine** is essential for effective pain management in sickle cell crisis, including the severe chest pain associated with acute chest syndrome. - Adequate pain control helps reduce patient distress and can indirectly prevent worsening of the crisis by reducing stress-induced sympathetic activation. *Hydroxyurea* - **Hydroxyurea** is a long-term disease-modifying therapy for sickle cell anemia, increasing the production of **fetal hemoglobin (HbF)**, which reduces sickling. - While crucial for preventing future crises and complications, it is not an acute treatment for an emergency like acute chest syndrome, as its effects take weeks to months to manifest.
Question 6: All of the following statements regarding this image are true except:
- A. Defect occurs usually between tenia coli and the blood vessel entering colonic wall
- B. They are a result of tractional force
- C. Most common site for this defect is sigmoid colon
- D. High fiber diet will reduce the incidence of this defect (Correct Answer)
Explanation: **_High fiber diet will reduce the incidence of this defect_** - This statement is **false**. High fiber intake is generally recommended for preventing diverticular disease and not for their treatment in this case. - While fiber can reduce the incidence of diverticulosis, it does not apply to the *defect itself*, which refers to existing diverticula. *Defect occurs usually between tenia coli and the blood vessel entering colonic wall* - This statement is **true**. Diverticula commonly arise at points where **colonic blood vessels** penetrate the muscular layers, creating weak spots. - These areas are anatomically predisposed to herniation due to the passage of **vasa recta** through the muscularis propria. *They are a result of tractional force* - This statement is **true**. Diverticula are generally classified as **false diverticula** (pseudodiverticula) because they are formed by the herniation of mucosa and submucosa through defects in the muscularis. - This herniation is primarily caused by **increased intraluminal pressure** working against the weakened colonic wall, rather than external traction. *Most common site for this defect is sigmoid colon* - This statement is **true**. The **sigmoid colon** is the most common site for diverticular disease due to its narrow lumen and higher intraluminal pressure. - This region experiences the greatest stress during fecal transit, predisposing it to the formation of these outpouchings.
Question 7: A 79-year-old male presented to the emergency department after a facial trauma. The patient had Parkinson's disease and atrial fibrillation and was on treatment with acetylsalicylic acid for AF. The image shows? (Recent NEET Pattern 2016-17)
- A. Hydrocephalus
- B. Pneumocephalus (Correct Answer)
- C. Intraventricular bleed
- D. Subarachnoid hemorrhage
Explanation: ***Pneumocephalus*** - The image clearly shows **intracranial air** (dark areas within the brain parenchyma and ventricles, indicated by arrows) following facial trauma, consistent with **pneumocephalus**. - **Pneumocephalus** often results from fractures of the skull base or paranasal sinuses, especially after trauma, allowing air to enter the intracranial space. *Hydrocephalus* - **Hydrocephalus** involves enlargement of the **ventricles** due to an accumulation of cerebrospinal fluid, which would appear as dark, but *fluid-filled* spaces, not air-filled. - No signs of significantly dilated ventricles are observed; instead, distinct air pockets are visible, which look black on CT. *Intraventricular bleed* - An **intraventricular bleed** would appear as **hyperdense (bright)** material (blood) within the ventricles on a CT scan, which is not seen here. - The appearance of the abnormalities is **hypodense (black)**, indicating air, not blood. *Subarachnoid hemorrhage* - **Subarachnoid hemorrhage** is characterized by **hyperdense (bright)** blood filling the subarachnoid spaces, particularly the sulci and basal cisterns. - The image displays **hypodense** areas consistent with air within the brain, not diffuse bright areas of blood in the subarachnoid space.
Question 8: Identify the lesion. (Recent NEET Pattern 2016-17)
- A. Right supranuclear lesion (Correct Answer)
- B. Left supranuclear lesion
- C. Right infranuclear lesion
- D. Left infranuclear lesion
Explanation: ***Right supranuclear lesion*** - The image shows **forehead sparing** with weakness predominantly in the lower face on the viewer's left side (patient's right side). This pattern is characteristic of a **supranuclear lesion**, where the contralateral motor cortex lesion affects the lower facial muscles more significantly due to bilateral innervation of the upper facial muscles. - Since the facial weakness is on the **right side of the face** (the lower part of her face is sagging to the left, indicating right-sided weakness), the lesion is in the contralateral (left) motor cortex or its descending pathways, leading to a right-sided supranuclear facial palsy. *Left supranuclear lesion* - A left supranuclear lesion would cause **right-sided facial weakness** affecting primarily the lower face, with forehead sparing. The image shows weakness on the patient's right side, meaning the lesion is on the contralateral side, which is the left motor cortex. Therefore, while the weakness is on the right side of the face, the lesion itself is on the contralateral left side, making this option incorrect as it specifies the lesion on the same side as the observed weakness. - Supranuclear lesions affecting the left side of the brain would manifest as right-sided facial weakness. *Right infranuclear lesion* - An **infranuclear lesion** (e.g., Bell's palsy) would affect the **entire half of the face**, including the forehead, leading to an inability to wrinkle the forehead on the affected side. This is not observed in the image, as the forehead appears somewhat spared. - An infranuclear lesion on the right would cause complete paralysis of the **right half of the face**, affecting both upper and lower facial muscles. *Left infranuclear lesion* - A left infranuclear lesion would present as **complete paralysis** of the **entire left side of the face**, including the forehead and eye closure. The image clearly demonstrates **forehead sparing** and weakness primarily affecting the lower face, ruling out an infranuclear lesion. - This type of lesion would involve the facial nerve itself after it exits the brainstem, leading to ipsilateral weakness of all facial muscles.
Question 9: A 55-year-old diabetic patient develops sudden onset hemiparesis and facial asymmetry. NCCT scan shows:
- A. Hyperdense MCA sign (Correct Answer)
- B. Cystic encephalomalacia
- C. Subarachnoid hemorrhage
- D. Lobar hemorrhage
Explanation: ***Hyperdense MCA sign*** - The image exhibits a **bright (hyperdense) area** within the Sylvian fissure, indicated by the white arrow, representing a **thrombus occluding the middle cerebral artery (MCA)**. This is a direct sign of acute **ischemic stroke**. - Clinical presentation of sudden onset hemiparesis and facial asymmetry in a diabetic patient strongly suggests an **ischemic stroke**, and the hyperdense MCA sign on NCCT confirms a proximal vessel occlusion. *Cystic encephalomalacia* - This refers to the **end stage of an infarct**, where brain tissue is replaced by **CSF-filled cysts** and gliosis, appearing as hypodense areas. - This finding would indicate an **old stroke**, not an acute event causing sudden neurological deficits. *Subarachnoid hemorrhage* - This condition involves **blood in the subarachnoid space**, appearing as hyperdensity within the **sulci and basal cisterns**. - While it features hyperdensity, the location in the image (within the Sylvian fissure, consistent with MCA) and the patient's symptoms are not typical for isolated subarachnoid hemorrhage. *Lobar hemorrhage* - A lobar hemorrhage is an **intraparenchymal bleed** within a lobe of the brain, appearing as a **focal, well-defined hyperdense lesion within the brain parenchyma**. - The hyperdensity in the image is linear and located within a vascular structure, consistent with an occluded vessel rather than a parenchymal bleed.
Question 10: A 35-year-old woman presents with breathlessness at rest. She also complains of a skin lesion on nose which has increased in size for last 6 months. What is the diagnosis?
- A. Sarcoidosis (Correct Answer)
- B. Phakomatosis
- C. Pulmonary lymphagiomatosis
- D. DRESS syndrome
Explanation: ***Sarcoidosis*** - Sarcoidosis is a multisystem **granulomatous disease** that commonly involves the lungs (causing **breathlessness**) and skin (manifesting as **lesions on the nose**, such as lupus pernio). The chest X-ray likely shows lung involvement like **bilateral hilar lymphadenopathy** or interstitial infiltrates. - The combination of **pulmonary symptoms** and characteristic **skin lesions** in a young to middle-aged adult is highly suggestive of sarcoidosis. *Phakomatosis* - Phakomatoses are a group of syndromes characterized by tumors or malformations of the skin, nervous system, and sometimes other organs. - While they can have skin lesions (e.g., neurofibromas, angiomas) and sometimes central nervous system or visceral involvement, **breathlessness is not a primary or typical presenting symptom**, and their CXR findings are usually normal unless there is specific lung involvement not characteristic of sarcoidosis. *Pulmonary lymphangiomatosis* - Pulmonary lymphangiomatosis is a rare, benign disease involving the proliferation of **lymphatic vessels** within the lung parenchyma, mediastinum, and pleura. - While it can cause breathlessness, **skin lesions on the nose are not a feature** of this condition, making it an unlikely diagnosis in this clinical context. *DRESS syndrome* - **DRESS (Drug Rash with Eosinophilia and Systemic Symptoms) syndrome** is a severe adverse drug reaction characterized by a widespread skin rash, fever, eosinophilia, and internal organ involvement (e.g., liver, kidneys). - While it presents with a skin lesion and systemic symptoms, the **onset is usually acute** following drug exposure, and the skin lesion on the nose described as increasing in size over 6 months is not typical for DRESS. Additionally, the pulmonary involvement differs from granulomatous disease.